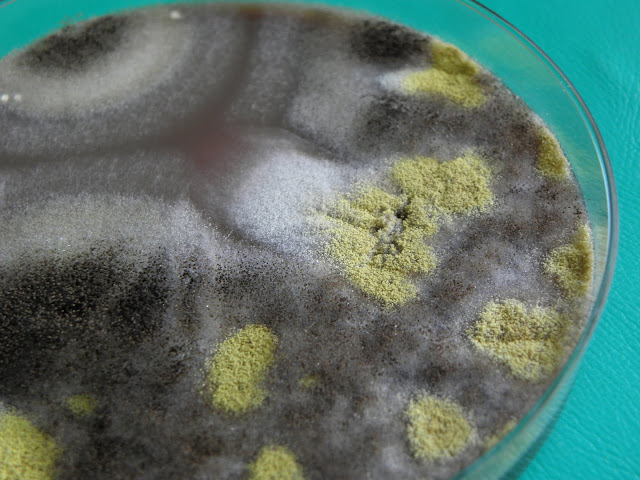

|
| Amostras de secreções respiratórias (lavado e aspirado) de doente proveniente de consulta externa. |
Sem história clínica prévia de consulta ou internamento.
A informação sobre a cultura foi telefonada referindo o médico assistente que não havia suspeita clínica específica para este tipo de achado laboratorial.
 |
| Colónias de Aspergillus niger e flavus e de Nocardia spp. (aspirado brônquico - Gelose sangue) |
 |
| Colónias de Aspergillus niger e flavus e de Nocardia spp. (lavado broncoalveolar - Gelose sangue) |
 |
| Nocardia spp. pormenor |
|
| Aspergillus niger e flavus - pormenor |
 |
| Hifas septadas - gram directo da amostra (ampliação 500x) |
 |
| Hifas septadas ramificadas - gram (500x) |
 |
| Hifa septadas ramificada - gram (500x) |
 |
| Nocardia spp. - gram (500x) |
 |
| Hifa septada - gram (500x) |
 |
| Nocardia spp. - gram (500x) |
 |
| Nocardia spp. e Hifas septadas - gram (500x) |
Material científico obtido e editado por:
Dr. Rui Tomé e Dr. Gilberto Marques